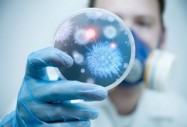
вирус вирус

Международна група учени-вирусолози откриха универсален подход за лечение на грип. Става дума за 20 нови, с помощта на които грипният вирус се разпространява по човешкото тяло. Блокирането на тези белтъци позволява да се спре развитието на заболявания, независимо от мутациите на вируса.
Традиционно лекарите лекуват грипа с препарати, които блокират непосредствено вируса. Макар и да са полезни, много пациенти престават да реагират на тези препарати, защото вирусите и най-вече този на грип А, могат да мутират. Това ги прави устойчиви към съществуващите лекарствени средства.
Нашите усилия са съсредоточени към търсене на неизменни елементи в човешкото тяло, които се използват от вирусите за по-нататъшно разпространение и разрастване в пълномащабна инфекция обяснява Самит Чандра от екипа изследователи.
Същността е в това, че грипните вируси не могат да се възпроизвеждат самостоятелно. Затова те се внедряват в елементи на организма, които използват за по-нататъшен растеж и разпространение. Ето защо е напълно логично да ограничим достъпа към тези елементи.
В рамките на тази теория учените открили двайсетте нови протеини – потенциални мишени. Главният за вирусите белтък е UBR4. Когато неговата активност в човешките клетки се блокира, вирусът повече не може да се развива.

Коментари